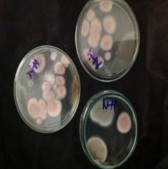
Hình 3 22 Ảnh hưởng của nguồn N lên số lượng bào tử nấm Purpureocillium 2

Hình 3.17: Ảnh hưởng của pH lên sự hình thành số lượng bào tử nấm Purpureocillium lilacinum
Bảng 3.4: Ảnh hưởng của pH đến số lượng bào tử nấm Purpureocillium lilacinum
Số lượng bào tử (pH 6) (bào tử/ ml) | Số lượng bào tử (pH 6.5) (bào tử/ ml) | Số lượng bào tử (pH 7) (bào tử/ ml) | Số lượng bào tử (pH 7.5) (bào tử/ ml) | ||
1 | 51600000 | 23400000 | 46000000 | 30800000 | |
2 | 50000000 | 26600000 | 34000000 | 33200000 | |
3 | 49800000 | 26400000 | 34000000 | 30600000 | |
4 | 14400000 | 23000000 | 22000000 | 25200000 | |
5 | 14000000 | 24600000 | 32000000 | 27000000 | |
6 | 14400000 | 25600000 | 24000000 | 14000000 | |
7 | 25400000 | 13600000 | 11000000 | 30000000 | |
8 | 25000000 | 17400000 | 7400000 | 40000000 | |
9 | 29000000 | 11200000 | 13200000 | 38000000 | |
10 | 9400000 | 10400000 | 10000000 | 3800000 | |
11 | 9800000 | 6400000 | 17400000 | 6600000 | |
12 | 10000000 | 4800000 | 7600000 | 5400000 | |
13 | 5000000 | 7000000 | 6600000 | 5200000 | |
14 | 5400000 | 7400000 | 7800000 | 2800000 | |
15 | 3200000 | 5400000 | 10200000 | 3200000 | |
16 | 3200000 | 5000000 | 9800000 | 4600000 | |
17 | 6600000 | 3800000 | 6000000 | 5200000 | |
18 | 3200000 | 4400000 | 4000000 | 2800000 | |
19 | 3200000 | 2800000 | 5800000 | 3600000 | |
20 | 6800000 | 6200000 | 1000000 | 2800000 | |
21 | 6000000 | 5400000 | 800000 | 1800000 | |
22 | 5600000 | 6600000 | 1200000 | 2800000 | |
23 | 5200000 | 4000000 | 800000 | 5200000 | |
24 | 6000000 | 4200000 | 4600000 | 3000000 | |
25 | 2000000 | 2600000 | 2800000 | 3800000 | |
26 | 2600000 | 4000000 | 6400000 | 3200000 | |
27 | 2000000 | 6000000 | 1600000 | 1000000 | |
pH | Số mẫu | Trung bình (bào tử) | Sự khác biệt | ||
Số lượng bào tử pH 6.5 | 27 | 1.06741E7 | X | ||
Số lượng bào tử pH 7 | 27 | 1.21481E7 | X | ||
Số lượng bào tử pH 7.5 | 27 | 1.24296E7 | X | ||
Có thể bạn quan tâm!
-
Môi Trường Phân Lập, Giữ Giống Nấm Purpureocillium Lilacinum (Môi Trường Potato Glucose Agar-Pga ) -
Phương Pháp Nghiên Cứu Ảnh Hưởng Của Môi Trường Nuôi Cấy Lên Sinh Khối Và Số Lượng Bào Tử Của Nấm Purpureocillium Lilacinum -
Kết Quả Khảo Sát Khả Năng Kiểm Soát Tuyến Trùng Meloidogyne Sp. Trong Diều Kiện In Vitro -
Đồ Thị Khảo Sát Ảnh Hưởng Nguồn C Lên Sinh Khối Nấm Purpureocillium Lilacinum -
Nghiên cứu phân lập nấm Purpureocillium Lilacinum để phòng trừ tuyến trùng bướu rễ Meloidogyne SP - 9 -
Nghiên cứu phân lập nấm Purpureocillium Lilacinum để phòng trừ tuyến trùng bướu rễ Meloidogyne SP - 10
Xem toàn bộ 84 trang tài liệu này.
27 | 1.36593E7 | X |
Số lượng bào
16000000
14000000
12000000
10000000
8000000
6000000
4000000
2000000
0
13659259
12148148 12429630
10674074
pH6 pH6.5 pH7 pH7.5
pH
Bào tử
Hình 3.18: Biểu đồ thể hiện ảnh hưởng của pH đến số lượng bào tử nấm Purpureocillium lilacinum
Đối với sự hình thành bào tử thì chúng tôi nhận thấy ở giá trị pH 6 cho số lượng bào tử cao nhất là 13659259 bào tử/ ml và đạt số lượng bào tử thấp nhất tại giá trị pH 6.5 ( 10674074 bào tử/ ml). Tuy nhiên qua phân tích bằng phần mềm Stargraphic cho thấy không có sự khác biệt về số lượng bào tử thu được giữa các nhóm giá trị pH.
Từ kết quả phân tích trong bảng 3.4 và hình 3.18 cho chúng tôi kết luận rằng sự thay đổi giá trị pH không có ý nghĩa trong sự hình thành sinh khối và số lượng bào tử của nấm Purpureocillium lilacinum.
3.4.2 Ảnh hưởng của nguồn Nitơ và nguồn Cacbon
a. Ảnh hưởng của nguồn Nitơ
Chúng tôi tiến hành nuôi cấy nấm Purpureocillium lilacinum trong môi trường lỏng Czapek- Dox trong các bình tam giác 250ml (100ml môi trường/bình) nhưng lần lượt thay thế cao nấm men bằng các nguồn Nitơ khác nhau như: KNO3, NaNO3, (NH4)2SO4.
Hình 3. 19: Ảnh hưởng của nguồn N lên sinh khối và số lượng bào tử nấm
Purpureocillium lilacinum
KNO3 NaNO3
(NH4)2SO4
Hình 3. 20: Sinh khối nấm Purpureocillium lilacinum trên các nguồn N khác nhau
Bình | Cao nấm men (g) | KNO3 (g) | NaNO3 (g) | (NH4)2SO4 (g) |
1 | 0.7039 | 0.1694 | 0.1396 | 0.1905 |
2 | 0.7655 | 0.2587 | 0.1817 | 0.1848 |
3 | 0.6775 | 0.1710 | 0.1356 | 0.1841 |
4 | 0.7109 | 0.1040 | 0.1759 | 0.1591 |
5 | 0.5246 | 0.1464 | 0.0959 | 0.2261 |
6 | 0.7911 | 0.1353 | 0.0812 | 0.1444 |
Bảng 3.5: Ảnh hưởng của nguồn N đến sinh khối nấm Purpureocillium lilacinum
0.8193 | 0.1317 | 0.1038 | 0.1984 | |||
8 | 0.6452 | 0.2005 | 0.1744 | 0.1640 | ||
9 | 0.7882 | 0.3298 | 0.2445 | 0.1489 | ||
Số mẫu | Trung bình (g) | Sai số | Sự khác biệt | |||
NaNO3 | 9 | 0.148067 | 0.0916788 | X | ||
(NH4)2SO4 | 9 | 0.177811 | 0.0262158 | X | ||
KNO3 | 9 | 0.182978 | 0.0710664 | X | ||
Cao nấm men | 9 | 0.714022 | 0.0515726 | X | ||
| ||||||
7
Hình 3. 21: Đồ thị thể hiện ảnh hưởng của nguồn N đến sinh khối nấm Purpureocillium lilacinum
Kết quả trình bày trong bảng 3.5 và hình 3.21 cho thâý nấm Purpureocillium lilacinum có thể sinh trưỏng trên tất cả nguồn N từ N vô cơ như: KNO3, NaNO3, (NH4)2SO4 đến nguồn N hũư cơ như: cao nấm men. Trong đó, sinh khối nấm Purpureocillium lilacinum đạt giá trị cao nhất khi được nuôi cấy trong môi trường có nguồn N là cao nấm men (0.714022g/ ml) và đạt giá trị thấp nhất trong môi trường có (NH4)2SO4.
Qua kết quả phân tích số liệu bằng phần mềm Stargraphic cho thấy sự thay đổi nguồn N có ảnh hưởng đến sự hình thành sinh khối nấm Purpureocillium lilacinum. sinh khối giữa các nhóm N khác nhau có sự khác biệt rất rò ràng: giữa nguồn N hữu cơ là cao nấm men khác biệt hẳn so với nguồn N vô cơ là: KNO3, NaNO3, (NH4)2SO4. Còn giữa các nguồn N vô cơ với nhau không có sự khác biệt về sinh khối nấm Purpureocillium lilacinum. Nguyên nhân của sự khác biệt giữa 2 nhóm nguồn N có thể do ngoài việc cung cấp protein cao nấm men
cón chứa thêm các thành phần khác như: vitamin, chitin (là một trong những thành phần tham gia cấu trúc vách tế bào nấm sợi) có vai trò trong việc chuyển hoá các chất, tham gia hình thành sinh khối nấm Purpureocillium lilacinum.
Hình 3. 22: Ảnh hưởng của nguồn N lên số lượng bào tử nấm
Purpureocillium lilacinum
Bảng 3.6: Ảnh hưởng của nguồn N lên số lượng bào tử nấm Purpureocillium lilacinum
Cao nấm men (bào tử/ ml) | KNO3 (bào tử/ ml) | NaNO3 (bào tử/ ml) | (NH4)2SO4 (bào tử/ ml) | |
1 | 3800000 | 5800000 | 1800000 | 3200000 |
2 | 1800000 | 5200000 | 1200000 | 200000 |
3 | 5000000 | 1600000 | 2000000 | 800000 |
4 | 4800000 | 6600000 | 1400000 | 200000 |
5 | 5400000 | 4600000 | 2000000 | 200000 |
6 | 3600000 | 6000000 | 1200000 | 400000 |
5800000 | 6400000 | 5400000 | 1600000 | ||
8 | 4600000 | 5600000 | 4600000 | 400000 | |
9 | 3200000 | 5400000 | 4800000 | 200000 | |
10 | 3600000 | 2600000 | 5000000 | 3800000 | |
11 | 1000000 | 1000000 | 2200000 | 400000 | |
12 | 1400000 | 3600000 | 3200000 | 200000 | |
13 | 3400000 | 4000000 | 5200000 | 200000 | |
14 | 1200000 | 7800000 | 1400000 | 3600000 | |
15 | 4000000 | 1800000 | 3000000 | 1800000 | |
16 | 4600000 | 3000000 | 3200000 | 400000 | |
17 | 5400000 | 1800000 | 2800000 | 400000 | |
18 | 2600000 | 2600000 | 2800000 | 200000 | |
19 | 3000000 | 1000000 | 2400000 | 200000 | |
20 | 2400000 | 800000 | 4400000 | 400000 | |
21 | 1200000 | 1400000 | 2800000 | 600000 | |
22 | 2800000 | 2400000 | 5200000 | 400000 | |
23 | 1600000 | 1000000 | 5000000 | 200000 | |
24 | 1800000 | 2600000 | 2800000 | 800000 | |
25 | 3600000 | 4400000 | 3000000 | 400000 | |
26 | 2600000 | 2600000 | 8000000 | 200000 | |
27 | 2800000 | 3600000 | 5200000 | 600000 | |
Số mẫu | Trung bình (bào tử/ ml) | Sự khác biệt | |||
(NH4)2SO 4 | 27 | 814815. | X | ||
Cao nấm men | 27 | 3.22222E6 | X | ||
NaNO3 | 27 | 3.40741E6 | X | ||
KNO3 | 27 | 3.52593E6 | X | ||
7
4000000
3500000
3000000
2500000
2000000
1500000
1000000
500000
0
3525926
3222222
3407407
814815
Cao nấm
men
KNO3
NaNO3 (NH4)2SO4
Nguồn N
Bào tử
Hình 3. 23: Biểu đồ khảo sát ảnh hưởng của nguồn N lên số lượng bào tử nấm
Purpureocillium lilacinum
Kết quả từ bảng 3.6 và hình 3.23 cho số lượng bào tử nấm Purpureocillium lilacinum đạt giá trị cao nhất khi sử dụng nguồn N là KNO3 (3525926 bào tử/ ml) và đạt giá trị thấp nhất khi sử dụng nguồn N là (NH4)2SO4 (814815bào tử/ml). Sự thay đổi nguồn N cũng ảnh hưởng rò ràng đến sự hình thành bào tử nấm Purpureocillium lilacinum điều đó thể hiện qua sự khác biệt về số lượng bào tử giữa nguồn N là (NH4)2SO4 với các nguồn N khác: cao nấm men, KNO3, NaNO3.
Khác với sự hình thành sinh khối, sự hình thành bào tử thường xảy ra trong điều kiện môi trường khắc nghiệt, thiếu thốn do đó có thể thấy rằng khi nuôi cấy trong môi trường sử dụng nguồn N là KNO3 lại cho kết quả cao hơn khi sử dụng nấm men. Tuy nhiên qua phân tích số liệu không cho thấy sự khác biệt giữa KNO3 và cao nấm men đến số lượng bào tử nấm Purpureocillium lilacinum. Do đó, chúng tôi chọn cao nấm men là nguồn N cho thí nghiệm tiếp theo.
b. Ảnh hưởng của nguồn Cacbon
Chúng tôi tiến hành nuôi cấy nấm Purpureocillium lilacinum trong môi trường lỏng Czapek-Dox Broth trong các bình tam giác 250ml (100ml môi trường/bình) nhưng lần lượt thay thế nguồn C glucose bằng: saccharose, tinh bột.
Kết quả thu được
Glucose Saccharose

Tinh bột
Hình 3. 24: Ảnh hưởng của nguồn C lên sinh khối nấm
Purpureocillium lilacinum
Bảng 3.7: Ảnh hưởng nguồn C lên sinh khối nấm Purpureocillium lilacinum
Glucose (g) | Saccharos(g) | Tinh bột(g) | |
1 | 0.7618 | 0.9068 | 0.7186 |
2 | 0.8579 | 0.7700 | 0.7260 |
3 | 0.6601 | 0.8591 | 0.7068 |
4 | 0.9686 | 1.4147 | 0.6882 |
5 | 0.8125 | 0.9698 | 0.4943 |
6 | 0.7071 | 1.0474 | 0.5248 |
7 | 0.7555 | 0.9947 | 0.7597 |
8 | 0.6320 | 0.6926 | 0.4827 |
9 | 0.6627 | 0.7064 | 0.5180 |
Số mẫu | Trung bình (g) | Sai số | Sự khác biệt | |
tinh bột | 9 | 0.624344 | 0.108659 | X |
glucose | 9 | 0.757578 | 0.221359 | X |
saccharose | 9 | 0.929056 | 0.115439 | X |
0.9 | 0.929055556 | |
0.8 | 0.757577778 | |
0.7 | ||
0.6 | 0.624344444 | |
0.5 | ||
0.4 0.3 0.2 | Sinh khối trung bình | |
0.1 | ||
0 | glucose saccarose tinh bột Nguồn C | |







